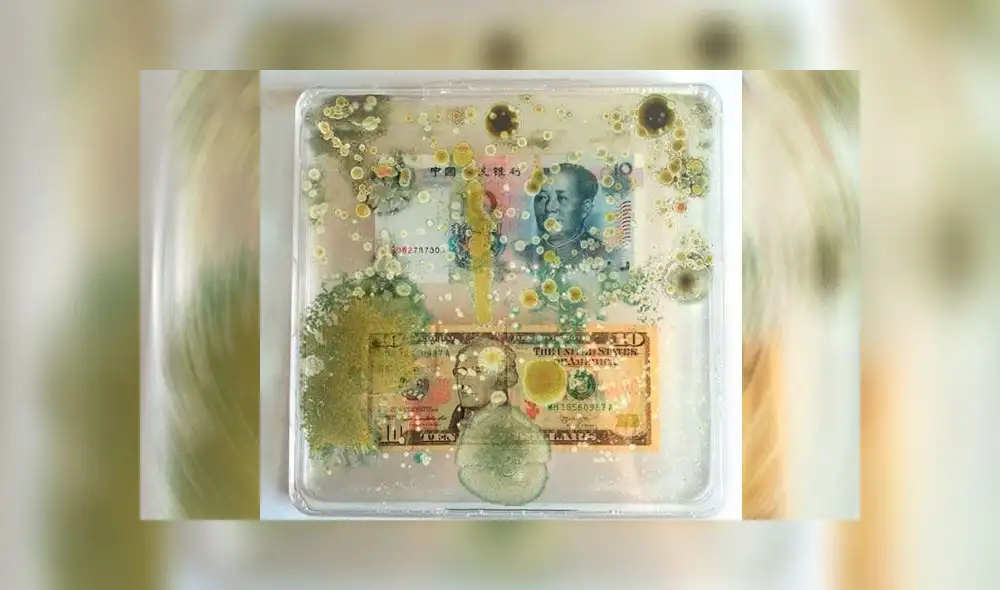
Estudio demuestra que cada billete tiene más de 3000 bacterias de la boca y los genitales

Estudio demuestra que cada billete tiene más de 3000 bacterias de la boca y los genitales
Un especialista indicó que las personas no saben cuán sucio es el dinero por lo que recomendó el lavado de manos con frecuencia para evitar la transferencia de organismos.
- Este es el volcán de América Latina más cercano al Sol que supera al Everest pese a sus casi 9.000 metros de altura
- El país de América Latina que rompe record histórico y se consolida como líder mundial en producción de plata
Una investigación realizada por el Centro de Genoma y Biología de Sistemas de la Universidad de Nueva York de Estados Unidos determinó que cada billete tiene más de 3,000 tipos de bacterias.
Este informe que realizó dicha casa de estudios indicó que gran parte de los microbios provienen de la boca, piel y genitales de las personas que manipulan el dinero.
TE RECOMENDAMOS
JOSÉ DOMINGO PÉREZ RESPONDE TRAS AMENAZAS DE KEIKO FUJIMORI | LA VERDAD A FONDO CON PEDRO SALINAS
A través de las muestras que tomó la universidad, el artista Ken Rinaldo pudo exhibir los billetes en su exposición llamada “Borderless Bacteria”, realizada en la capital de Alemania, Berlín. Allí exhibió el dinero en cajas transparentes y cómo los microbios, de diferentes colores, se presentan.
Con esta muestra, el artista intenta explicar las bacterias que están dentro de cada billete. “Estas pueden vivir semanas enteras en estos trozos de papel”, manifestó Rinaldo para Código Nuevo.
Ken explicó que su obra permite que los espectadores tengan “una mirada divertida entre el conflicto que existe entre dos países”.
PUEDES VER: Mujer besa a su expareja que intentó matarla con cinco disparos durante el juicio: “Perdoné porque lo amo"
Asimismo, el artista afirmó que “los cultivos bacterianos, hongos y virus que encuentran transporte en los sistemas de intercambio monetario no respetan ni entienden las fronteras. No hay visas o pasaportes para microbios que se enganchan de manos, narices y genitales. El dinero viaja libremente a nivel nacional e internacional. El efectivo es un vector de cultivos biológicos comercializados mundialmente”.
Por otro lado, el especialista del Centro de Genoma y Biología de Sistemas de la Universidad de Nueva York de Estados Unidos, Jane Cartlon, señaló que las personas no tienen en cuenta lo sucio que es el dinero, por lo que “deben continuar lavándose las manos con frecuencia para evitar la transferencia de organismos”.